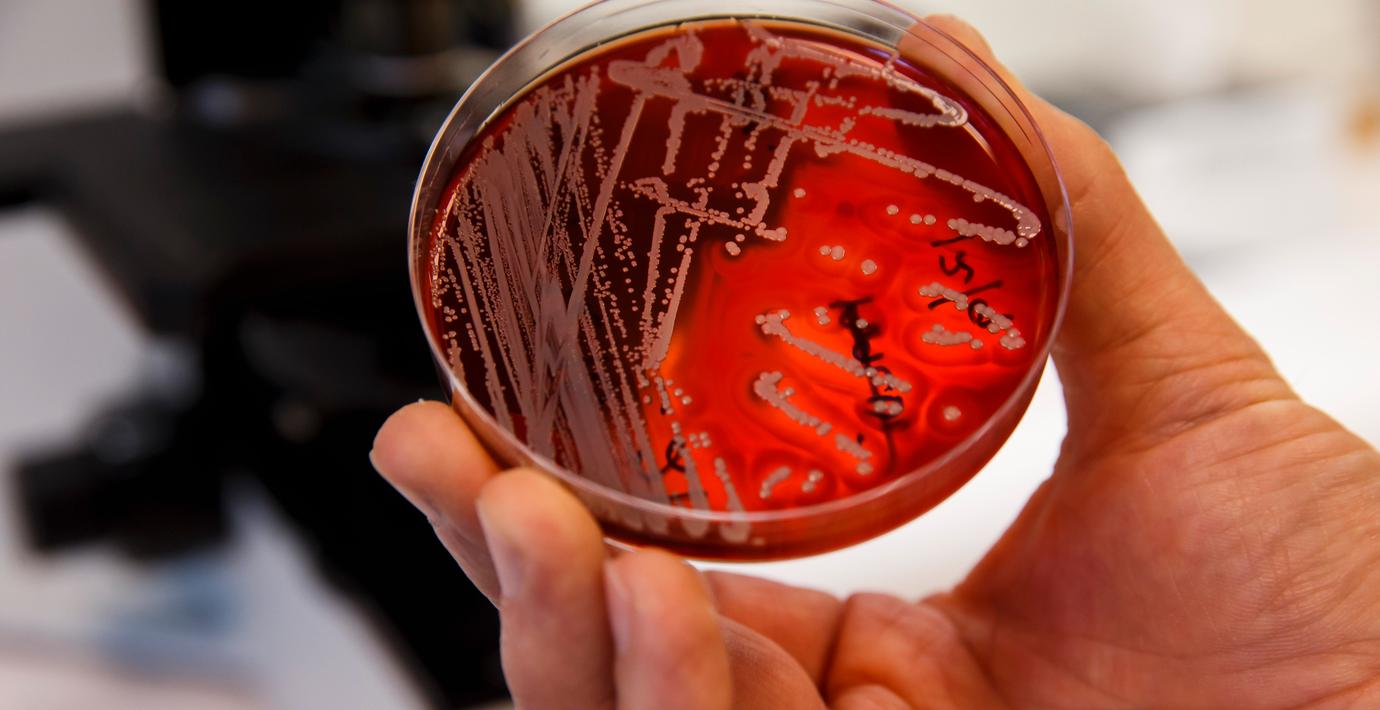

”Omöjlig uppgift att försöka segra över bakterier”
Varje år dör hundratusentals människor på grund av resistenta infektioner – för att både rutiningrepp och avancerad vård ska kunna fortsätta så är det avgörande med fungerande antibiotika.
Det skriver en grupp debattörer – bland dem förra moderata handelsministern Ewa Björling – på SvD:s debattsida. De menar att det är en omöjlig uppgift att försöka segra över bakterierna genom att utveckla nya antibiotika.
”Bakterierna har evolutionen på sin sida”, skriver de. Debattörerna föreslår i stället ett ökat fokus på förebyggande arbete: insatser som kan bromsa och kontrollera resistensutvecklingen.
Under onsdagen inleds World antimicrobial awareness week, en kampanj för att uppmärksamma problemet.
Debattörerna
Cecilia Tilli, generalsekreterare, The Foundaiton to prevent antibiotic resistance
Peter Rothschild, styrelseordförande, The Foundaiton to prevent antibiotic resistance
Ewa Björling, med dr, docent virologi, före detta handelsminister
Stig Wall, professor emeritus epidemiologi, hälso och sjukvårdsforskning, Umeå universitet



